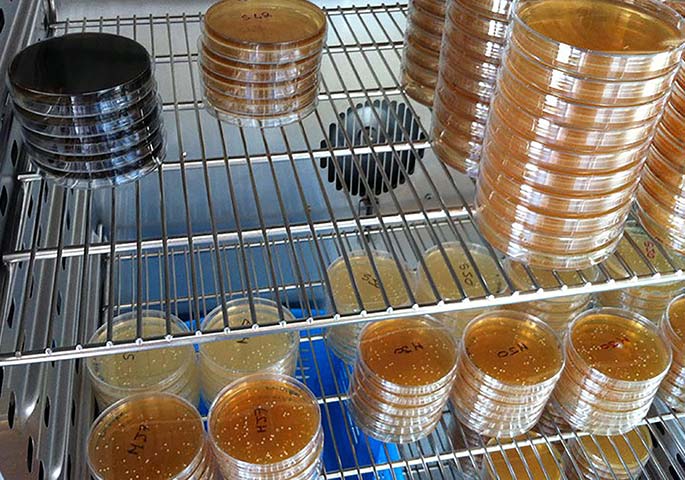

案例研究: 超低温冰箱 UF V系列应用于美容产品的检测

任务设置:
- 检验和评定原材料
- 微生物学和分析学测试
- 评定新配方的毒理学风险
- 微生物防腐测试
- 细胞和组织培养
- 美容产品成品的保质期
BINDER解决方案:
- 最低 –86°C 的安全保存
- 简单的数据管理
- 个性化的访问控制
- 技术服务
- 可靠的消毒方案
- 可复现的生长条件
- 温度均匀性高
- 清洁简单

只需看一眼我们的浴室,就知道我们每天使用了多少美容产品。洗发水、沐浴露、面霜、身体润肤乳、牙膏或者化妆品 – 在文明世界,一系列的美容产品已术语每个家庭的标配。我们作为消费者完全相信这些产品的内含物质。但是,在这些我们每天接触的瓶瓶罐罐中到底装有哪些成分呢?THOR Personal Care Sas 公司专门致力于检验和评定各种美容产品的原材料和成分。
保存有机病原体微生物菌株
THOR Personal Care 公司坐落于巴黎的Compiègne,是业务遍布全球的 THOR集团的子公司。在 2400 m² 的公司内,除了开发和销售工作外,还运营着针对技术服务、应用开发和毒理学体外测试的实验室。在此,THOR Personal Care 公司专注于新型防腐剂、软化剂、硅树脂和四元衍 生 物 的 研究和开发工作 。 THORPersonal Care 公司从一开始就使用BINDER 产品进行微生物学和分析学测试。甚至在借助 THOR IVT(体外毒理学 )方法评定新型配方的毒理学风时,BINDER 产品具有核心作用。“我们是 BINDER 超低温冰箱 UF V 500 的首批用户之一,对此我们感到非常骄傲”,THOR Personal Care 公司技术服务与法规事务经理 Stéphane Sellam 如此说 道 。 “ 我 们 使 用 低 温 冰 箱 保 存 有 机病原体微生物菌株。在此我们尤其重视可靠性。”
最低达 -86 C 的保存温度
实验室的微生物防腐测试必须满足现行标准。满足标准的前提是所用病菌的可控性和可靠性,尤其是在传染性和生化特性方面。在 -20°C 的温度下保存 2 年后 就 不 应 再 使 用 的 培 养 基 可 以 在B I N D E R 超 低 温 冰 箱 内 , 在 最 低 达-86°C 的超低保存温度下毫无问题地保存和使用 5 年。通过相同的方式保存未污染的美容产品样品(来自市面上或者生产流程中)中的微生物。THOR 藉此为美容产品行业相关的微生物建立一个培养基收集库。
微生物技术服务
在拟订试验报告时,公司也使用 BINDER培养箱。此时使用指定的接种物污染美容产品,并放置在恒定的温度下。在一个月的时间内测量和记录病原体的存活率。根据不同防腐体系的结果,可以针对每个美容产品配方找到合适的防腐剂。这就是THOR Personal Care 公司为客户提供的微 生 物 技 术 服 务 的 基 础 产 品 。 THOR Personal Care 同时使用 18 种 BINDER产品。其中的实验室装备包括用于细胞和组织培养的 CB 系列气体培养箱,以及用于微生物培养的 KB、BD 和 BF 产品。此外,实验室使用 BINDER 干燥箱验证其试验报告的可靠性和可复现性。在 Cofrac和 GLP 认证的毒理学体外测试中,实验室尤其需要这些特性。而 BINDER 恒温恒湿箱 KMF 115 则被用于确定美容产品成品的保质期。“温度和湿度之间保持恒定 的 相 互 作 用 在 该 过 程 中 非 常 重 要 ” ,Stéphane Sellam 如此描述恒温恒湿箱的使用。“我们特别重视最佳的技术服务和 BINDER 设备的高质量。”